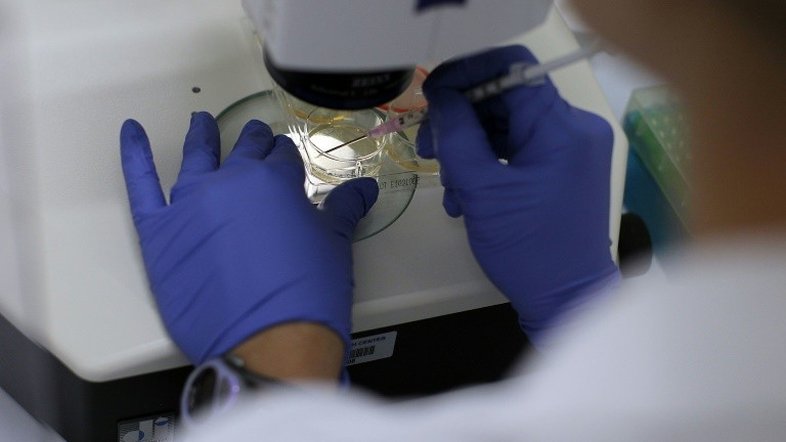

Um transplante de células-tronco funciona melhor do que remédios para estender a vida de pessoas com esclerodermia, uma doença autoimune na qual a pele enrijece e os órgãos se quebram, disseram pesquisadores nesta quarta-feira (3).
As descobertas publicadas no New England Journal of Medicine apontam para uma nova forma de tratamento dessa enfermidade incurável que afeta 2,5 milhões de pessoas em todo o mundo, a maioria delas mulheres em idade fértil.
“A esclerodermia enrijece a pele e os tecidos conjuntivos, e em sua forma severa leva à falência dos órgãos, mais frequentemente dos pulmões”, assinalou o autor principal Keith Sullivan, professor de Medicina e Terapia Celuluar na Duke University.
“Nesses casos severos, terapias convencionais com remédios não são muito eficazes em um longo período e, por isso, novas abordagens são a prioridade”.
O estudo escolheu aleatoriamente 36 pacientes com esclerodermia nos Estados Unidos e no Canadá para fazer o transplante de células-tronco. Primeiro, foram submetidos a uma alta dose de quimioterapia e radiação em todo o corpo para eliminar completamente o seu sistema imunológico.
Em seguida, foram reinfundidos com as células-tronco com seu sangue que foram removidas e tratadas para eliminar os glóbulos brancos defeituosos.
Outros 39 pacientes foram escolhidos aleatoriamente para receber injeções intravenosas de ciclofosfamida por 12 meses, que é um tratamento imunossupressor convencional para esclerodermia severa.
Os pacientes submetidos ao transplante de células-tronco viram uma “melhoria significativa na sobrevivência”, informou o estudo, que durou 10 anos e foi realizado em 26 universidades de Estados Unidos e Canadá.
Os pacientes do grupo que recebeu as células-tronco eram mais propensos a ver melhorias em sua sobrevivência, na função dos órgãos, na qualidade de vida e no enrijecimento da pele.
“A sobrevivência global aos 72 meses foi de 86% após o transplante, contra 51% após o de ciclofosfamida”, segundo o relatório.
“Esses resultados mostram que os indivíduos com um prognóstico ruim de esclerodermia podem melhorar e viver mais, e esses avanços parecem duradouros”, disse Sullivan.
No final do estudo, apenas 9% do grupo do transplante voltou a tomar medicamentos contra a esclerodermia, em comparação com 44% no grupo de tratamento convencional.
No entanto, o tratamento com células-tronco apresentou maior risco de morte e efeitos colaterais mais graves em curto prazo, incluindo infecções e baixa contagem de glóbulos.
Após 54 meses, 3% dos que fizeram o transplante morreram. Ninguém no grupo do ciclofosfamida morreu pelo tratamento.
“Os pacientes e seus médicos devem pesar cuidadosamente os prós e contras do tratamento intensivo com transplante de células-tronco, mas isso pode, espero, definir um novo padrão nesta doença autoimune devastadora”, assinalou Sullivan.
)